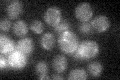
YHR002W
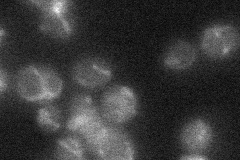
YHR002W

View description
Mitochondrial carrier protein involved in the accumulation of CoA in the mitochondrial matrix; homolog of human Graves disease protein; does not encode an isozyme of Leu4p, as first hypothesized
Localization:
Intensity:
Fold change:
Significance:
-
C’ GFP library in SD
mitochondria14.92 -
N' NOP1pr-GFP in SD

mitochondria29.8467 -
N' TEF2pr-mCherry in SD

mitochondria31.1704 -
N' NATIVEpr-GFP in SD
mitochondria20.3624 -
N' TEF2pr-VC and Cyto-VN in SD

#N/A0 -
C’ GFP library in SD+DTT

mitochondria16.91.13No -
C’ GFP library in SD+H2O2

mitochondria14.510.97No -
C’ GFP library in Starvation Media

mitochondria22.431.5No -
C’ GFP library on the background of Pup2-DaMP

mitochondria -
C’ GFP library on the background of CCT mutant

mitochondria15.67871.05054No
